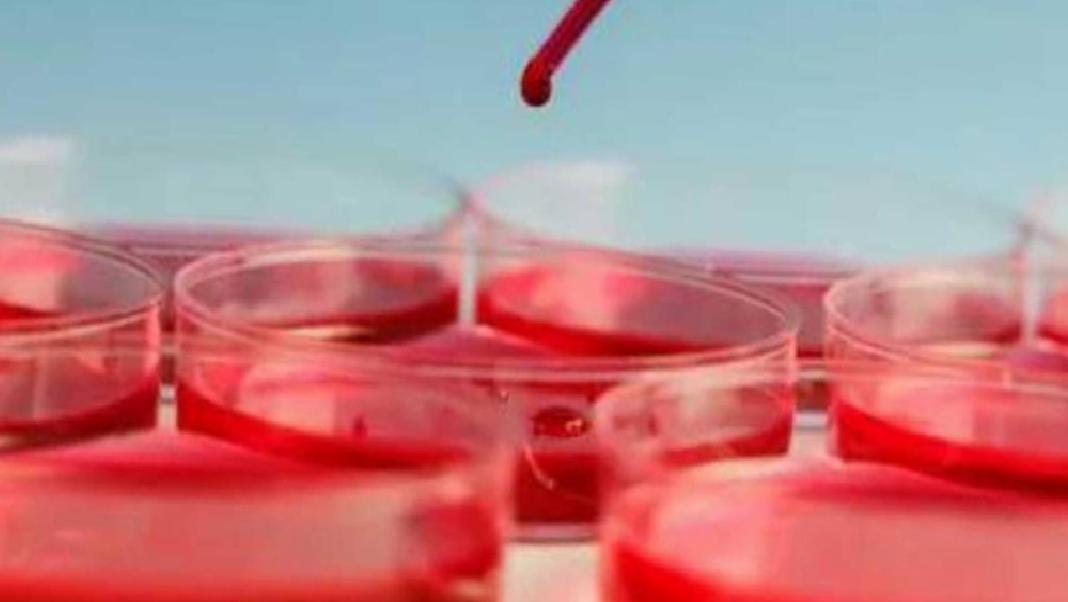
Kansızlığa İyi Gelen Besinler

Kansızlık (Anemi) Nedir? Nedenleri ve Beslenme Önerileri

Kansızlık (Anemi) Nedir?

Kansızlık, vücutta yeterli sayıda sağlıklı kırmızı kan hücresi bulunmadığında meydana gelen bir sağlık sorunudur. Bu hücreler, organ ve dokulara oksijen taşıma işlevini üstlenerek, vücudun genel sağlığı için kritik bir rol oynar. Kırmızı kan hücrelerinin sayısındaki azalma, genellikle vücudun bu hücreleri üretiminde veya ömründe yaşanan sorunlar nedeniyle kansızlık durumunu ortaya çıkarır.

Dünya genelinde anemi prevalansı %24,8 oranında görülmekte olup, özellikle okul öncesi çocuklar bu konuda en yüksek risk grubunu oluşturmaktadır. Bu yaş grubunda anemi oranı dünya çapında %47 olarak tahmin edilmektedir.
Kansızlık Nedenleri

Kansızlık, genellikle aşağıdaki faktörlerden biri veya birkaçının bir araya gelmesiyle gelişir:

- Yeterli kırmızı kan hücresi üretilememesi
- Kanama sonucu kırmızı kan hücrelerinin kaybında artış
- Kırmızı kan hücrelerinin normalden daha hızlı yok edilmesi
Kansızlık Türleri ve Nedenleri

Demir Eksikliği Anemisi: En yaygın anemi türüdür ve demir eksikliğinden kaynaklanır. Demir, kemik iliğinde kırmızı kan hücreleri için gerekli olan hemoglobini üretmek için gereklidir. Yetersiz demir alımı, hamilelik, ağır adet kanamaları, mide ülserleri ve bazı kanser türleri bu tür anemiye neden olabilir.
Vitamin Eksikliğine Bağlı Anemi: Kırmızı kan hücrelerinin sağlıklı bir şekilde üretimi için demir, folat ve B12 vitaminlerine ihtiyaç vardır. Bu vitaminlerin eksikliği, kırmızı kan hücresi üretimini olumsuz etkileyebilir. Özellikle B12 vitamini emilimindeki sorunlar, pernisiyöz anemi adı verilen bir duruma yol açabilir.
Kronik Hastalık Anemisi: Kanser, HIV/AIDS, romatoid artrit ve böbrek hastalığı gibi iltihabi hastalıklar, kırmızı kan hücrelerinin üretimini engelleyebilir.
Aplastik Anemi: Nadir görülen ve hayatı tehdit eden bir anemi türüdür. Vücut yeterince kırmızı kan hücresi üretmediğinde ortaya çıkar. Enfeksiyonlar, bazı ilaçlar, otoimmün hastalıklar ve toksik kimyasallara maruz kalma aplastik aneminin nedenleri arasında yer alır.
Kemik İliği Hastalıklarına Bağlı Anemiler: Lösemi ve miyelofibroz gibi hastalıklar, kemik iliğinde kan hücresi oluşumunu etkileyerek kansızlığa yol açabilir. Bu durumlar hafif olabileceği gibi, hayatı tehdit edici de olabilir.
Hemolitik Anemiler: Kırmızı kan hücrelerinin yıkımı, üretimden daha hızlı gerçekleştiğinde görülür. Bazı kan hastalıkları, kırmızı kan hücresi yıkımını artırarak hemolitik anemiye neden olabilir. Bu durum kalıtsal olabileceği gibi sonradan da gelişebilir.
Orak Hücre Anemisi: Kalıtsal bir hemolitik anemi türüdür ve anormal şekilli kırmızı kan hücrelerinin üretimine yol açar. Bu anormal hücreler, vaktinden önce ölür ve kronik kırmızı kan hücresi yetersizliğine neden olur.
Kronik Kurşun Zehirlenmesine Bağlı Anemi: Kurşun zehirlenmesi, anemiye yol açabilen önemli bir faktördür.

Kansızlığa İyi Gelen Besinler
Kansızlıkla mücadelede, genellikle demir açısından zengin besinlerin tüketilmesi büyük önem taşır. Ayrıca, demir emilimini artıran C vitamini içeren yiyecekler de dikkate alınmalıdır. İşte kansızlığa iyi gelen başlıca besinler:
- Kırmızı Et: Demir bakımından zengindir ve kolay emilen bir demir formu içerir.
- Karaciğer: Demir ve B12 vitamini açısından oldukça zengindir.
- Ispanak: Bitkisel kaynaklı demir içerir; C vitamini ile birlikte tüketildiğinde emilimi artar.
- Baklagiller: Mercimek, nohut ve fasulye gibi baklagiller iyi birer demir kaynağıdır.
- Yumurta: Demir ve B12 vitamini içerir.
- Kuru Meyveler: Kuru üzüm, kuru kayısı ve kuru erik demir açısından zengindir.
- Fındık ve Tohumlar: Özellikle kabak çekirdeği, badem ve kaju demir içerir.
- Tam Tahıllar: Yulaf, kinoa ve kepekli tahıllar demir açısından faydalıdır.
- Deniz Ürünleri: İstiridye, midye ve balık türleri yüksek demir içeriğine sahiptir.
- C Vitamini Kaynakları: Portakal, mandalina, limon, çilek, kivi ve kırmızı biber gibi C vitamini açısından zengin yiyecekler, demirin emilimini artırır.
Uzman Görüşleri

Diyetisyenler ve Beslenme Uzmanları: Kansızlık durumunda demir yönünden zengin gıdaların tüketilmesi önemle tavsiye edilir. Demir eksikliği bulunan bireylerin, demirin emilimini engelleyen çay ve kahve gibi içeceklerden kaçınmaları gerektiği vurgulanır.
Hematologlar: Demir eksikliği anemisi tanısı konan hastalara demir takviyesi önerilmektedir. Bu süreçte, diyetle yeterli demir alımının desteklenmesi gerektiği belirtilir. Ayrıca, B12 ve folik asit eksikliklerinin de kansızlığa yol açabileceği ifade edilmektedir.
Uzman Doktorlar: C vitamini ile demir emilimini artırmak ve hayvansal kaynaklı demir tüketimini artırmak, kansızlık tedavisinde etkili olabilir. Aşırı demir eksikliği durumunda ise tıbbi tedavi gerekebileceği için bir doktora danışılması önemli bir adımdır.











